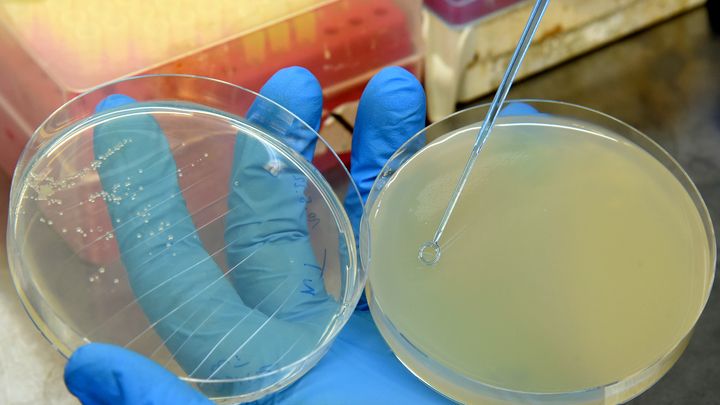
В Пентагоне заверили о мирной направленности биолабораторий на Украине

В Пентагоне заверили о мирной направленности биолабораторий на Украине
Оборонное ведомство США выпустило пресс-релиз, в котором отмечается, что Вашингтон легально оказывал поддержку 46 украинским биологическим объектам в рамках мирных проектов медицинской и сельскохозяйственной сферы.
Отмечается, что США работали над повышением биологической безопасности и защиты Украины. Американские специалисты также якобы помогали украинским учреждениям здравоохранения на протяжении последних двадцати лет.
Амариканцы заверили, что сотрудничество происходило с соблюдением норм международного законодательства. В партнерстве также принимала участие Всемирная организация здравоохранения.
В Пентагоне добавили, что у Киева нет ядерной, химической или биологических программ военной направленности. Её билолаборатории ничем не отличаются от подобных научных в других странах мира, сказали в Вашинтоне.